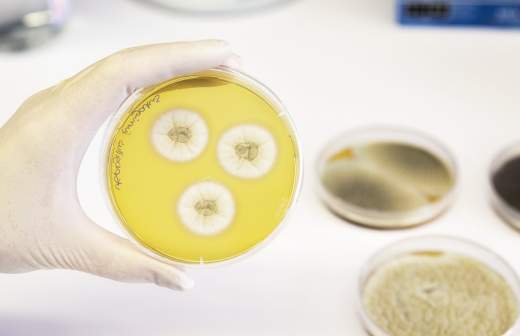

Ученый опроверг опасность грибов на стволах деревьев в Подмосковье

Биохимик Александр Гришин в беседе с «Известиями» 20 августа опроверг сообщения о том, что на стволах деревьев в Московской области появились опасные для здоровья человека паразиты, к которым нельзя прикасаться.
Накануне, 19 августа, агентство городских новостей «Москва» со ссылкой на пресс-службу регионального министерства экологии и природопользования сообщило, что паразитирующая на деревьях ликогала древесинная — якобы очень ядовитый гриб, а прикосновение его спор к организму якобы может спровоцировать ряд заболеваний, включая онкологические.
«Это абсолютно не соответствует действительности, думаю, это какой-то фейк. Ликогалла древесинная — абсолютно обычный неядовитый гриб. Их еще называют слизовиками, потому что когда у них молодые тела, они умеют ползать», — сказал Александр Гришин.
По его словам, этот безобидный гриб питается разложившейся древесиной. К нему можно прикасаться без всякой опаски. Есть их действительно не рекомендуется, просто потому что они невкусные.
15 августа в комитете по туризму Московской области рассказали, где в регионе можно найти белые грибы. Гражданам предложили съездить в леса по Белорусскому, Казанскому, Киевскому, Курскому, Ленинградскому, Павелецкому и Горьковскому направлениям.